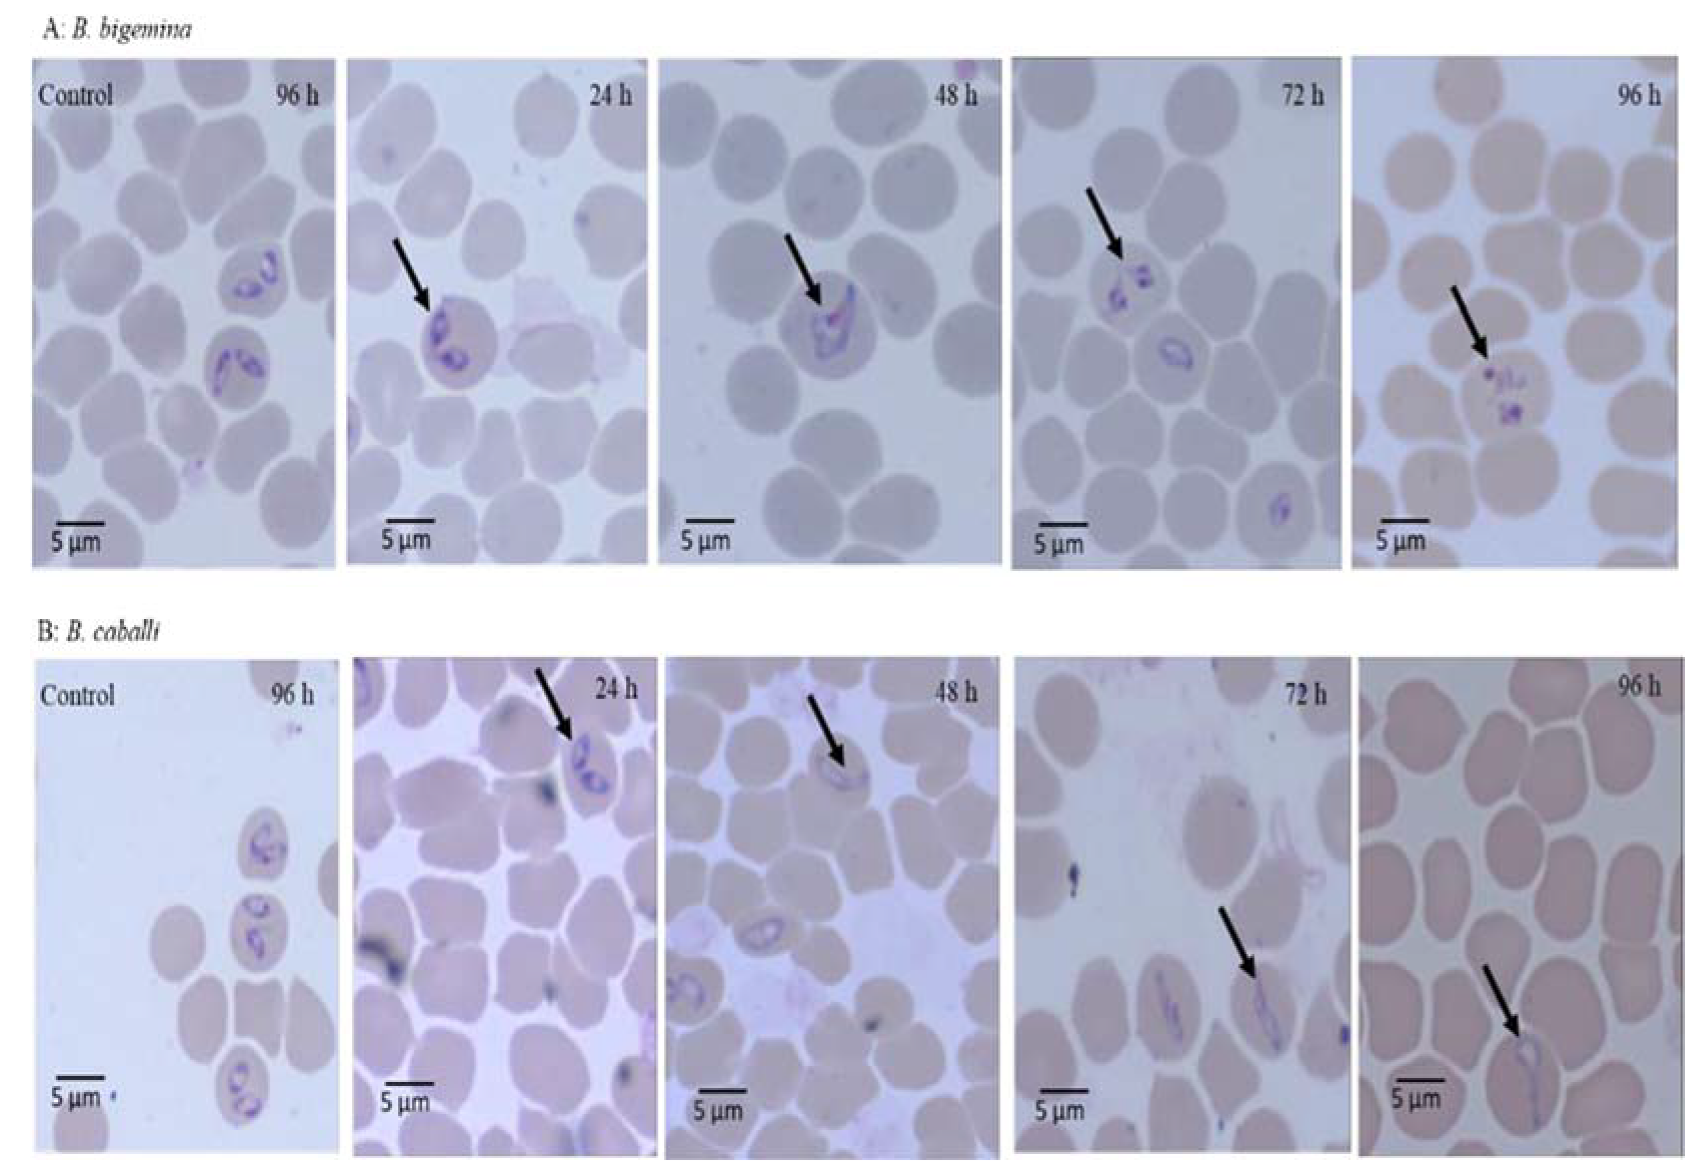
Molecules 25 00996 g003

Abstract
Cinnamomum verum is a commonly used herbal plant that has several documented properties against various diseases. The existing study evaluated the inhibitory effect of acetonic extract of C. verum (AECV) and ethyl acetate extract of C. verum (EAECV) against piroplasm parasites in vitro and in vivo. The drug-exposure viability assay was tested on Madin-Darby bovine kidney (MDBK), mouse embryonic fibroblast (NIH/3T3) and human foreskin fibroblast (HFF) cells. Qualitative phytochemical estimation revealed that AECV and EAECV containing multiple bioactive constituents namely alkaloids, tannins, saponins, terpenoids and remarkable amounts of polyphenols and flavonoids. AECV and EAECV inhibited B. bovis, B. bigemina, B. divergens, B. caballi, and T. equi multiplication at half-maximal inhibitory concentrations (IC50) of 23.1 ± 1.4, 56.6 ± 9.1, 33.4 ± 2.1, 40.3 ± 7.5, 18.8 ± 1.6 µg/mL, and 40.1 ± 8.5, 55.6 ± 1.1, 45.7 ± 1.9, 50.2 ± 6.2, and 61.5 ± 5.2 µg/mL, respectively. In the cytotoxicity assay, AECV and EAECV affected the viability of MDBK, NIH/3T3 and HFF cells with half-maximum effective concentrations (EC50) of 440 ± 10.6, 816 ± 12.7 and 914 ± 12.2 µg/mL and 376 ± 11.2, 610 ± 7.7 and 790 ± 12.4 µg/mL, respectively. The in vivo experiment showed that AECV and EAECV were effective against B. microti in mice at 150 mg/kg. These results showed that C. verum extracts are potential antipiroplasm drugs after further studies in some clinical cases.
1. Introduction
Theileriosis and babesiosis are tick-transmitted diseases with significant economic impacts in the bovine and equine industries all over the world [1]. Babesia divergens and B. microti mainly affect cattle and rodents, respectively, and reveal zoonotic significance [2]. Babesia divergens is the main reason for babesiosis in Europe, mainly in immunocompromised humans, while B. microti is the main known etiologic agent responsible for human babesiosis in the USA. Babesia bovis, as well as B. bigemina, are the most pathogenic agents in cattle [1], while Theileria equi and Babesia caballi are considered the most devastating infections in horses. Horses and cattle that survive acute infections may become permanent sources for continuous transmission [3].
The prevention and control of babesiosis and theileriosis rely on vector control, the use of vaccines, and drugs available on the market [3,4]. Unfortunately, only a few drugs are available, such as a combination of clindamycin and quinine, atovaquone-azithromycin, diminazene aceturate (DA), and imidocarb dipropionate [5]. However, some human cases showed resistance to atovaquone and azithromycin combination, moreover, imidocarb dipropionate has shown strong toxicity to the host, and DA–resistant parasites have emerged [2,6]. Although several studies have documented the effectiveness of antipiroplasmic herbal extracts such as Syzygium aromaticum methanolic extract [7], methanolic Cuminum cyminum seeds extract and acetonic Myrtus communis roots [8], and methanolic Olea europaea and acetonic Acacia laeta [9] against the growth of piroplasm parasites, none of these extracts are used by veterinarians for the treatment of clinical cases [1]. Notably, there is an urgent and continuing need to identify alternative drugs to treat piroplasmosis.
Over the past few decades, research on herbal plants has provided modern medicine with several useful chemical ingredients that have been used to manage various ailments. However, many people in developing countries, especially in Africa and Asia, still rely on crude herbal extracts to treat several human and animal ailments [10,11]. This is partly because these extracts are inexpensive and easily accessible [12]. Cinnamomum genus consists of thousands of species that are distributed all over the world and is considered as one of the most important and popular spices used in cooking as well as traditional and modern medicines [13]. Cinnamomum verum, C. osmophloeum, C. cassia, C. camphora, C. burmannii, C. loureiroi and C. zeylanicum are the main economically important Cinnamomum species. Interestingly, they are commercially used for many medicinal purposes and in the perfume industry and can be included in various types of foodstuffs. Several reports have documented antiseptic, antiviral, antibacterial, antifungal, antidiabetic, hypocholesteremic, carminative, astringent, and blood purifier activities [13,14]. Recently, Zhang et al. [15] reported that C. cassia possesses many pharmacological activities, including antibacterial, anti-inflammatory, antitumor, anti-obesity, analgesic, antidiabetic, antiviral, cardiovascular protective, neuroprotective, cytoprotective and immunoregulatory properties. The effective role of cinnamon in the inhibition of different diseases is attributed to the presence of various chemical constituents in high concentrations. For instance, camphor is one of the significant bioactive molecules extracted from C. camphora that has been used in pharmaceuticals, mainly liniments and insecticides and shows antidiabetic affect [16]. Barros et al. [17] documented that essential oils extracted from C. zeylanicum bark, significantly enhanced the osmotic fragility curve of red blood cells (RBCs), and promoting toxic effects on RBCs membranes. Another research on C. osmophloeum (C. osmophloeum) indicated that the essential oil from cinnamon leaves contains a high concentration of cinnamaldehyde. (E)-cinnamaldehyde is considered one of the main bioactive molecules of essential oil extracted from C. zeylanicum that is responsible for its activity [14]. Cinnamaldehyde is the major constituent of Cinnamomum spices that possesses anaesthetic, antipyretic, antiallergic, metal ion chelating, lipo-protective, antioxidant, antibacterial and antiproliferative activity against several human cancer cell lines including leukemia, ovarian, breast (T47D) and lung (NCI-H322) cancer cell lines by inhibiting cancer progression [18].
Cinnamomum verum is a plant commonly used in traditional medicine. C. verum belongs to the genus Cinnamomum, which includes about 250 species of plants distributed worldwide, especially in parts of Africa and Asia [13]. C. verum has several medicinal properties, such as anti-inflammatory, hypoglycemic, antibacterial, antioxidant, spasmolytic, antidiarrheal, antifungal, antitumor, analgesic, gastroprotective, anticancer, and anthelmintic ones [14,19,20]. Interestingly, recent studies have documented the antimalarial efficacy of C. verum extract [21,22]. However, to our knowledge, no data has been reported to show the efficacy of C. verum herbal extracts against the growth of piroplasm parasites. C. verum has shown several medicinal properties because it contains many phytochemical ingredients, such as cinnamic acid, cinnamaldehyde, cinnamate, and numerous polyphenols [23]. More recently, Kwan et al. [24] identified new compounds in ethanolic C. verum extract, such as chlorogenic acid, catechin, protocatechuic acid, icariin, aesculetin, and quercetin. Therefore, it is important to use an extraction method that can harvest the effective phytochemical molecules from the C. verum plant. Unfortunately, extraction solvents that include methanol, ethanol, acetone, and ethyl acetate have shown variation in the amount and types of bioactive molecules harvested [25]. This study aimed to assess the effectiveness of acetonic extract of C. verum (AECV) and ethyl acetate extract of C. verum (EAECV) against the growth of B. bovis, B. bigemina, B. divergens, B. caballi and T. equi using the in vitro fluorescence assay. Furthermore, the chemotherapeutic potential of AECV and EAECV on B. microti in mice was investigated.
2. Results
2.1. Plant Extraction, Phytochemical and Total Phenolic and Flavonoid Contents Evaluation of C. verum Extracts
The yield percentage of the C. verum extracts was 8.34% w/w dry matter and dark in color. Preliminary examination of AECV and EAECV pointed to the existence of different phytoconstituents such as tannins, saponins, alkaloids and terpenoids that may be responsible for their pharmacological activities. Considerable amounts of phenolic and flavonoid contents were observed in AECV and EAECV. Notably, AECV (76.5 ± 0.94 mg of GAE/g DW) showed higher total phenolic content than EAECV (64.4 ± 1.57 mg of GAE/g DW). Moreover, AECV (43.7 ± 1.8 mg of CAE/g DW) had the higher total flavonoid content than EAECV (40.3 ± 0.9 mg of CAE/g DW).
2.2. Gas Chromatography-Mass Spectrometry (GC-MS) Analysis
The GC-MS analysis of AECV and EAECV revealed the existence of 17 and 26 phytochemical compounds, respectively. The identified chemical composition of AECV is shown in Table 1 and Figure S1 and represented 17 compounds, while the identified chemical composition of EAECV is shown in Table 2 and Figure S2 and represented 26 compounds.
Table 1.
The chemical composition of AECV by GC-MS.
Table 2.
The chemical composition of EAECV by GC-MS.
The phytochemical compounds’ identification was established on the basis of the peak area, and retention time. The active principles with their retention time (RT) and percentage of peak area (%) are expressed in Figure 1A,B.

Figure 1.
Gas chromatography-mass spectrometry analysis in the AECV (A) and EAECV (B).
2.3. The Growth Inhibitory Effect of AECV and EAECV In Vitro
The preliminary evaluation of C. verum extracts was performed to detect their efficacy on bovine and equine RBCs. The proliferation of B. bigemina and B. caballi did not significantly differ between AECV- and EAECV-treated RBCs and untreated RBCs for the two tested species (data not shown). For the growth-inhibitory effect, AECV (Figure 2A) and EAECV (Figure 2B) affected the multiplication of B. bovis, B. bigemina, B. divergens, B. caballi, and T. equi in a dose-dependent manner. B. bovis multiplication was suppressed significantly (t-test: t(6) = 2.412, p < 0.0001) at 6.25 µM AECV, whereas B. divergens, B. bigemina and B. caballi multiplication was suppressed significantly (t-test: t(6) = 1.765, p < 0.0001) at 6.25 µM AECV and T. equi multiplication was suppressed significantly (t-test: t(6) = 3.583, p < 0.0001) at 3.125 µM AECV (Figure 2A). EAECV inhibited the in vitro multiplication of B. bovis (t-test: t(6) = 3. 589, p = 0.01), B. bigemina and B. divergens significantly (t-test: t(6) = 1.960, p = 0.001) at 3.125 µM. EAECV inhibited the multiplication of B. caballi and T. equi significantly (t-test: t(6) = 0.919, p < 0.0001) at 3.125, 6.25 µM, respectively (Figure 2B).
Figure 2.
The dose-response curves acetonic extract of C. verum (AECV) (A) and ethyl acetate extract of C. verum (EAECV) (B) against Babesia and Theileria parasites in vitro. The curves showing the growth inhibition of B. bovis, B. bigemina, B. divergens, B. caballi and T. equi treated with various concentrations of AECV and EAECV. The result was determined by the fluorescence assay after 96 h of incubation. The values obtained from three separate trials were used to determine the IC50’s using the non-linear regression (curve fit analysis) in GraphPad Prism software (GraphPad Software Inc. San Diego, CA, USA).
AECV and EAECV exhibited IC50 values of 23.1 ± 1.4, 56.6 ± 9.1, 33.4 ± 2.1, 40.3 ± 7.5, and 18.8 ± 1.6 µg/mL and 40.1 ± 8.5, 55.6 ± 1.1, 45.7 ± 1.9, 50.2 ± 6.2, and 61.5 ± 5.2 µg/mL against B. bovis, B. bigemina, B. divergens, B. caballi, and T. equi, respectively (Table 3). The IC50 values of DA, methanolic Syzygium aromaticum (MESA) and methanolic Olea europaea extracts (MEOE) that inhibited the multiplication of B. bovis, B. bigemina, B. divergens, B. caballi and T. equi were 0.25, 0.11, 0.35, 0.003, and 0.37 µg/mL and 109.8 ± 3.8, 8.7 ± 0.09, 76.4 ± 4.5, 19.6 ± 2.2, and 60 ± 7.3μg/ mL and 107.1 ± 9.2, 47.7 ± 2.3, 101.1 ± 8.9, 105.5 ± 11.1, 19.3 ± 2.1 µg/mL, respectively (Table S1).
Table 3.
IC50 and selectivity index of C. verum extracts.
2.4. The Viability of Parasites Treated with AECV and EAECV and Morphological Changes of Treated Parasites
In the presence of 2 × IC50 EAECV, the regrowth of B. bovis, B. bigemina, B. divergens, B. caballi, and T. equi was completely suppressed. AECV at 2 × IC50 completely suppressed the regrowth of B. bovis and B. divergens, while B. caballi, B. bigemina, and T. equi could not regrow at 4 × IC50 (Table 4).
Table 4.
The viability of parasites treated with Cinnamomum verum extracts.
The micrographs of EAECV-treated B. bigemina and B. caballi and of AECV-treated B. bovis and T. equi are shown in Figure 3 and Figure 4, respectively. At 24 and 48 h, all captured micrographs revealed spindle shapes dividing parasites compared to the piriform shape of untreated B. bovis, B. bigemina, and B. caballi, while dot-shaped residues of deadly parasites were observed within the erythrocytes at 72 and 96 h.
Figure 3.
Morphological changes observed in ethyl acetate C. verum extract-treated B. bigemina and B. caballi. Light micrographs of ethyl acetate C. verum extract-treated B. bigemina and B. caballi in an in vitro culture taken after 24, 48, 72, and 96 h. The arrows show the spindle shapes of dividing parasites at 24 and 48 h, while at 72 and 96 h, dot-shaped remnants of dying parasites were observed as compared to the piriform shape of normal B. bigemina and B. caballi (control).
Figure 4.
Morphological changes observed in acetonic C. verum extract-treated B. bovis and T. equi. Light micrographs of acetonic C. verum extract-treated B. bovis and T. equi in an in vitro culture taken after 24, 48, 72, and 96 h. B. bovis–treated parasites at 24 and 48 h appear spindle-shaped, while at 72 and 96 h, they appear dot-shaped as compared to the normal piriform shape of B. bovis (control). T. equi–treated parasites at 24 and 48 h appear smaller and pyknotic, while at 72 and 96 h, the dying parasites appeared dot-shaped as compared to the oval shape of T. equi (control).
At 24 and 48 h, T. equi parasites treated with AECV were smaller and pyknotic compared to the oval form of the untreated parasites. In subsequent micrographs taken at 72 and 96 h, the dying parasites appeared dot-shaped.
2.5. Toxicity of AECV and EAECV on Normal Cells
The cytotoxicity of C. verum extracts on host cells were estimated using MDBK, NIH/3T3, and HFF cell lines. AECV and EAECV showed EC50 values of 440 ± 10.6, 816 ± 12.7 and 914 ± 12.2 µg/L and 376 ± 11.2, 610 ± 7.7 and 790 ± 12.4 µg/mL on MDBK, NIH/3T3, and HFF cell lines, respectively. DA did not affect the viability of MDBK, NIH/3T3, and HFF cell viability even at 100 µg/mL, while MESA and MEOE affected the viability of MDBK, NIH/3T3, and HFF cell lines at EC50 894.7 ± 4.9, >1000 and >1000 µg/mL and 794.7 ± 41.9, ˃1500 and ˃1500 µg/mL, respectively (Additional file 1: Table S1). The highest selectivity indexes (the ratio of cell line EC50 to the parasite IC50) of the AECV and EAECV were found to be 23.4 times higher than the IC50 on T. equi, and 9.4 times higher than the IC50 on B. bovis, respectively (Table 3).
2.6. Combination Effect of Extracts In Vitro
Combinations of AECV and EAECV with DA and S. aromaticum and O. europaeae methanolic extracts were assessed in the in vitro cultures of B. bovis, B. bigemina, B. divergens, B. caballi, and T. equi. The combined treatment of AECV and EAECV with DA (Table 5) and MESA (Table 6) and MEOE (Table 7) was synergistic and additive against B. bovis, B. bigemina, B. divergens, B. caballi, and T. equi.
Table 5.
Combination effect of DA and C. verum extracts.
Table 6.
Combination effect of methanolic S. aromaticum and C. verum extracts.
Table 7.
Combination effect of methanolic O. europaea and C. verum extracts.
2.7. The In Vivo Chemotherapeutic Effect of AECV and EAECV
To examine the chemotherapeutic effects of EAECV and AECV in vivo, B. microti-infected BALB/c mice were treated with EAECV and AECV for five days after infection reach 1% parasitemia. Control group treated with double-distilled water (DDW) exhibited rapid growth of parasitemia reached 55.8% on day 8 post-infection (p.i.) and the parasitemia decreased gradually on the following days. In groups treated with EAECV or AECV, the level of parasitemia was cleared at a statistically significant lower percentage of parasitemia than that of the control group (ANOVA: F(1.988, 32.74) = 2.917, p < 0.0001 for 150 mg/kg AECV; ANOVA: F(2, 32.02) = 2.945, p < 0.0001 for 150 mg/kg EAECV) from days 6 to 12 p.i. Among all treated mice, the peak parasitemia level was 21.7% and 27.3% in 150 mg/kg AECV and EAECV, respectively on day 8 p.i. The peak parasitemia level was 9.1% in 25 mg/kg DA (Figure 5).
Figure 5.
Growth inhibition of C. verum extracts on B. microti in mice. Inhibitory effect of C. verum extracts on the growth of B. microti in mice, based on observations taken from five mice per experimental group. EAECV, ethyl acetate C. verum extract; AECV, acetonic C. verum extract. The arrow indicates 5 consecutive days of treatment. Asterisks indicate statistically significant (p < 0.05) differences of parasitemia between treated groups and the untreated control group based on one-way ANOVA Tukey’s test, available in the GraphPad Prism software. Parasitemia was calculated by counting infected RBCs among 2000 RBCs using Giemsa-stained thin blood smears. The data were the mean and standard deviation from two separate experiments.
The comparison of the hematology parameters during in vivo studies showed no significant difference in RBCs (Figure 6A), hemoglobin (Figure 6B), or hematocrit percentage (Figure 6C) for the groups treated with AECV or EAECV as compared to the DA-treated group on days 8 and 12. While statistically significant differences in the RBCs (ANOVA: F(3, 12.02) = 6.015, p < 0.002), HGB concentration (ANOVA: F(2.984, 11.61) = 4.978, p < 0.006), and HCT (ANOVA: F(3.103, 10.47) = 3.843, p < 0.01) was detected between the drug-treated groups and DDW group on days 8 and 12.
Figure 6.
RBCs, hemoglobin, and hematocrit changes in C. verum extract-treated mice. Graphs showing changes in the number of red blood cells (RBCs) (A), hemoglobin concentration (HGB) (B), and hematocrit percentage (HCT) (C) in mice treated with diminazene aceturate and two C. verum extracts. EAECA, ethyl acetate C. verum extract; AECA, acetonic C. verum extract. The arrow indicates 5 consecutive days of treatment. Asterisks indicate statistical significance (p < 0.05) based on one-way ANOVA Tukey’s test, available in the GraphPad Prism software. The data were the mean and standard deviation from two separate experiments (five mice per group).
3. Discussion
The current study documents the efficacy of various C. verum extracts, namely, acetonic and ethyl acetate against the in vitro growth of B. bovis, B. bigemina, B. divergens, B. caballi, and T. equi in vitro and on B. microti in vivo. Initially, AECV and EAECV were examined for the existence of various biologically active compounds and the preliminary and qualitative screening emphasized the presence of significant amounts of polyphenols, terpenoids, alkaloid, flavonoids, and tannin. It has been shown that all these secondary metabolites have many therapeutic and antiprotozoal properties against several parasites namely Plasmodium, Leishmania, Trypanosoma, Schistosoma and Trichomonas Vaginalis and they are known to be pharmacologically active components [26].
The GC-MS analysis was used to identify and detect phytochemical constituents present in AECV and EAECV. The analysis revealed that AECV consisted of 17 compounds and the main chemical components detected were (E)-cinnamaldehyde (52.87%), chromen-2-one (10.63%), o-methoxycinnamaldehyde, (5.04%), γ-muurolene (4.92%), cadina-1(10),4-diene (4.64%) and acetic acid cinnamyl ester (4.35%), while EAECV was found to possess 26 compounds and the main chemical components identified were (E)-cinnamaldehyde (53.81%), coumarin (9.92%), γ-muurolene (5.37%), p-methoxycinnamaldehyde, (4.91%), acetic acid cinnamyl ester (4.83%), cadina-1(10),4-diene (4.78%) and cinnamyl alcohol (4.27%). Our results indicating that EAECV consist of slightly higher percent of (E)-cinnamaldehyde, γ-muurolene, and acetic acid cinnamyl ester, suggesting that ethyl acetate is the better solvent of extraction. This finding is consistent with Dvorackova et al. [25] who revealed that different extraction solvents have shown variation in the amount and types of bioactive molecules harvested.
AECV and EAECV showed varying levels of effectiveness against all tested species. For instance, AECV was most effective against B. bovis, B. divergens, B. caballi and T. equi, while EAECV was most effective against B. bigemina. Different C. verum extracts exhibited varying IC50 values against Babesia and Theileria species, which implies that the mode of extraction is a key determinant of the effectiveness or concentration of active molecules in the final extract. Moreover, the preliminary and qualitative screening results showed that AECV contains higher total phenolic and flavonoid content than EAECV and these results explaining the highest antipiroplasmic and inhibitory effect of AECV. This finding was consistent with a previous study performed by Nkanwen et al. [21] who tested ethyl acetate/n-hexane C. verum extract for anti-plasmodial efficacy and showed an inhibitory effect on the Plasmodium falciparum enoyl-ACP reductase enzyme. More recently, Parvazi et al. [22] showed that aqueous C. verum extract possesses inhibitory activity against P. falciparum in vitro, by alteration of the following metabolites: l-aspartic acid, succinic acid, β-alanine, glutathione, and 2-methylbutyryl glycine.
Recently, several studies documented the antiprotozoal activities of different phytochemical molecules detected by our GC-MS analysis. For example, von Son-de Fernex et al. [27] and Williams et al. [28] documented the in vitro anthelmintic activity of 2H-chromen-2-one and cinnamaldehyde, the main chemical component in AECV and EAECV against Cooperia Punctata and the swine nematode Ascaris suum, whereas Kpadonou et al. [29] disclosed the antitrypanosomal efficacy of caryophyllene oxide against Trypanosoma brucei brucei with IC50 value of 17.67 µg/mL. Moreover, Bosquiroli et al. [30] proved antileishmanial activity of caryophyllene and caryophyllene oxide against promastigotes of L. infantum. In addition to that, Le et al. [31] reported the anti-protozoal activity of C. verum essential oil and its constituents (cinnamaldehyde and caryophyllene) against Leishmania, Plasmodium and Trypanosoma. Therefore, we hypothesized that cinnamaldehyde, caryophyllene, 2H-chromen-2-one, and caryophyllene oxide are the main active compounds responsible for the antipiroplasmic activity of C. verum extracts.
The viability assay showed that AECV and EAECV were effective against Babesia and Theileria parasites. This result was comparable with that of Parvazi et al. [22] who showed that aqueous C. verum extract inhibited the growth of P. falciparum by preventing amino acid biosynthesis through inhibiting carbon dioxide fixation and disabling the synthesis of alanine, aspartame, and glutamate. Based on this finding, we suggest that C. verum extracts have multiple mechanisms against piroplasm parasites. Compared with previous studies on the viability of treated piroplasm parasites, EAECV suppressed the regrowth of Babesia and Theileria parasites at lower concentrations than the methanolic extract of O. europaea and chalcone hydrate [6,9]. Furthermore, AECV suppressed the regrowth of B. bovis and B. divergens at lower concentrations than the methanolic extract of S. aromaticum [7]. Nevertheless, not all C. verum extracts completely inhibited the regrowth of piroplasm parasites at low concentrations. For instance, EAECV is able to clear all the parasites which indicate that the ethyl acetate extraction method harvested more bioactive molecules that can eliminate Babesia and Theileria parasites.
Morphological observations in micrographs of C. verum-treated parasites showed that the C. verum extract-treated Babesia and Theileria parasites were not able to eject and died inside the RBCs. Additionally, the malformations observed in the piroplasm parasites might be due to the ability of C. verum extracts to damage the parasite metabolome. The suggested mode of action for P. falciparum was reported previously by Parvazi et al. [22] who revealed that aqueous C. verum extract disrupts the thioredoxin and glutathione system, resulting in a change in the parasite metabolome, inhibiting its growth.
The experiments to determine cytotoxicity showed that C. verum extracts affected the viability of the MDBK, NIH/3T3, and HFF cell lines at a slightly high selectivity index. This means that the bioactive compounds that exist in C. verum extracts were more likely to affect piroplasm parasites than the host cells. C. verum extracts contain a mixture of polyphenols with cinnamaldehyde that plays a significant therapeutic role in cancer cell lines by depolarization of the mitochondrial membrane potential, leading to cellular apoptosis without cytotoxic activities on host cells [32]. One possible explanation of the modest selectivity index of AECV and EAECV is due to the presence of alkaloids and terpenoids [30,33]. The aforementioned results indicating the safety of C. verum extracts for the treatment of animals and humans following further clinical studies.
Drugs with a combination of C. verum extracts with DA, MESA, and MEOE were assessed in vitro against B. bovis, B. bigemina, B. divergens, B. caballi, and T. equi. The combined application of C. verum extracts with DA, MESA, and MEOE showed synergistic and additive effects. One possible explanation is that C. verum extracts contain many bioactive ingredients that may interact differently in combination treatments [23].
Acetonic and ethyl acetate C. verum extracts produced promising in vivo antibabesial activity. Oral administration of 150 mg/kg of AECV and EAECV resulted in 61.1% and 51.7% inhibition, respectively compared with 83.7% inhibition showed by 25 mg/kg DA on day 8 p.i. The growth inhibitory effects of AECV and EAECV on B. microti were lower than the 80 % inhibition revealed by 150 mg/kg MEOE, 64% inhibition shown by acetonic Acacia laeta extracts [9] and 69.2% shown by MESA [7]. However, the inhibitory efficacy of AECV on the multiplication of B. microti was higher than the 60% revealed by 150 mg/kg methanolic Peganum harmala seed extract, 55.1% inhibition noticed by 150 mg/kg ethanolic Artemisia absinthium leaf extract [34] and 42.4% inhibition shown by methanolic Camellia sinensis extract [7]. Furthermore, the inhibitory efficacy of EAECV on the multiplication of B. microti was higher than 42.4% shown by methanolic Camellia sinensis extract [7]. The chemosuppression effect produced by AECV and EAECV on B. microti may indicate the presence of potential compounds with higher antibabesial activity.
C. verum extracts have strong anti-inflammatory [15] and antioxidant effects and improve reduced glutathione synthesis in the liver [35,36]. Such medicinal effects are useful because piroplasmosis infection is related to reactive oxygen and nitrogen species overproduction, which leads to oxidative stress [37]. Thus, identifying the active compound is necessary for contriving a higher chemosuppression effect from these extracts for the future discovery of a novel potential drug against piroplasmosis. The limitation of this study is the use of the whole extract to confirm its antipiroplasmic efficacy, and it is recommended to assess the antipiroplasmic efficacy of the GC-MS identified compounds for the future discovery of a novel lead potential drug against piroplasmosis. As well, evaluate the actual mode of action employed against the recovery of piroplasm parasites.
4. Materials and Methods
4.1. Preparation of Extracts
4.1.1. Chemicals and Solvents
The extraction solvents, namely, 99.5% acetone (Nacalai Tesque, Kyoto, Japan) and 99.5% ethyl acetate (Chameleon Reagent, Osaka, Japan), were used to obtain C. verum extracts. Stock solutions (10 mM) in dimethyl sulfoxide (DMSO) of DA (Ciba-Geigy Japan Limited, Tokyo, Japan) and C. verum extracts were stored at –30 °C and used for antibabesiosis evaluation. Aluminum chloride (AlCl3; Sigma-Aldrich, Tokyo, Japan) was dissolved in distillate water and used to detect the total flavonoid in the C. verum extracts. The SYBR Green I (SGI) nucleic acid stain (10,000×, Lonza, Alpharetta, GA, USA) was used for fluorescence assay after mixing with the lysis buffer consisting of Tris (130 mM at pH 7.5), EDTA (10 mM), saponin (0.016% w/v), and Triton X-100 (1.6% v/v) which was filtered using a 0.22 µm polyethersulfone and kept at 4 °C.
4.1.2. Plant Material
Locally produced cinnamon bark C. verum (Ceylon cinnamon) was purchased from a spice store in Egypt, identified and voucher specimen number was placed by the members of the Department of Pharmacology and Chemotherapeutics, Faculty of Veterinary Medicine, Damanhour University, Egypt. The voucher specimen number of C. verum is A 0177107 (DPV). The bark was dried in an electric drying oven at 30 °C (Sanyo, Osaka, Japan) and pounded using a 60–80 mm mesh. The finely ground C. verum powder (100 g) was dissolved in 250 mL of each solvent (acetone and ethyl acetate) and then stirred at 25 °C for 72 h as described elsewhere [9,35]. The obtained solutions were filtered using Whatmann filter paper no. 1., concentrated using a rotary evaporator (RotavaporR-200/205, BUCHI®, Flawil, Switzerland) and lyophilized using a Freeze dry vacuum system (Labconco, Kansas City, MO, USA) [7,8]. Crude extracts were weighed followed by the addition of 1 mL of DMSO to 100 mg of the extract to be stored at −30 °C. The resulting extract weight was 8.34 g and the yield percentage was calculated using the following equation [38]:
4.1.3. Phytochemical Examination of Plant Extracts
AECV and EAECV were examined for the existence of terpenoids, saponins, tannins, and alkaloids using several qualitative tests described previously [39].
4.1.4. Determination of Total Phenolic Content
The concentration of total phenol present in AECV and EAECV was detected using the Folin-Ciocalteu (FC) reagent method as described elsewhere [40]. A volume of 0.5 mL of AECV and EAECV (1 mg/mL) was added to 1.5 mL of 10% FC reagent (diluted 1:10 with deionized water) and mixed for 5 min. After that, an aliquot (3 mL) of 7.5% Na2CO3 solution was added and further incubated at 30 °C for 2 h. Finally, the absorbance was calculated at 760 nm and the content of total phenolic compounds was detected from a gallic acid standard curve and expressed as mg/g gallic acid equivalent (GAE) of the dry weight of the extract (mg GAE/g DW).
4.1.5. Determination of Total Flavonoid Content
Aluminum chloride (AlCl3) colorimetric method was used for the examination of total flavonoid content in AECV and EAECV as previously determined [40]. Briefly, an aliquot (1 mL) of AECV and EAECV was added to 3 mL of solvent extracts, 3.8 mL of distilled water, 200 µL of 1 M potassium acetate and 200 µL of 10% AlCl3 and incubated for 30 min. The absorbance was measured at 420 nm and the flavonoid content was detected from a catechin standard curve and expressed as mg/g catechin equivalents of the dry weight of individual extract (mg CAE/g DW).
4.1.6. GC-MS Analysis
The chemical composition of AECV and EAECV was performed using a Trace GC-ISQ mass spectrometer (Thermo Scientific, Austin, TX, USA) with a direct capillary column TG–5MS (30 m × 0.25 mm × 0.25 µm film thickness) as previously described [1,41]. The column oven temperature was initially held at 50 °C and then increased by 5 °C/min to 250 °C withhold 1 min then increased to 300 at the rate of 30 °C /min. The injector temperatures were kept at 260 °C. Helium was used as a carrier gas at a constant flow rate of 1 mL/min. The solvent delay was 4 min and diluted samples of 1 µL were injected automatically using an AS3000 Autosampler coupled with GC in the split mode. EI mass spectra were collected at 70 eV ionization voltages over the range of m/z 50–650 in full scan mode. The ion source and transfer line were set at 250 °C and 270 °C, respectively. The components were identified by comparison of their retention times and mass spectra with those of WILEY 09 and NIST 11 mass spectral databases.
4.2. Parasites and Culture Conditions
Babesia bigemina Argentine strain, B. bovis Texas strain, B. divergens Germany strain, USDA strains of B. caballi and T. equi, and Munich strain of B. microti [41,42] were used in this study. The bovine and equine parasites used in this study were maintained in purified bovine or equine RBCs (collected from the animal farm of Obihiro University of Agriculture and Veterinary Medicine and stored at 4 °C) and incubated in a humidified chamber at 37 °C under an atmosphere of 5% CO2, 5% O2, and 90% N2 using a microaerophilic stationary-phase culture [6,7]. Babesia bovis and B. bigemina were grown in medium 199 (M199) supplemented with 40% bovine serum, B. divergens was grown in RPMI 1640 medium (Sigma-Aldrich) supplemented with 40% bovine serum, while T. equi was grown in M199 supplemented with 40% equine serum and 13.6 µg of hypoxanthine (ICN Biomedical Inc., Santa Ana, CA, USA) per mL. GIT medium supplemented with 40% equine serum was used for B. caballi cultivation. Amphotericin B (0.15 μg/mL), penicillin G (60 U/mL) and streptomycin (60 U/mL) (all from Sigma-Aldrich) were then prepared and added to all medium to prevent bacterial contamination.
4.3. Evaluation of the Impacts of AECV and EAECV on RBCs of Cattle and Horse
The hemolytic efficacy of AECV and EAECV on cattle and horse RBCs was evaluated in vitro as previously reported elsewhere [6,42]. Initially, AECV and EAECV extracts at 600 µg/mL were cultivated at 37 °C with purified bovine and equine RBCs for 3 h. Afterward, the pretreated-RBCs were washed three times with PBS and mixed with bovine and equine parasites. To monitor the parasitemia and any side effects as a result of the pretreatment, Giemsa-stained blood smears were prepared daily.
4.4. The In Vitro Growth Inhibitory Effects of AECV and EAECV
The in vitro Babesia fluorescent assay was carried out as previously reported elsewhere [42] to evaluate the inhibitory effects of AECV and EAECV. The stock supply of RBCs with 1% parasitemia was prepared by diluting parasite-infected RBCs (iRBCs) with uninfected RBCs. Briefly, in three separate trials, different concentrations of AECV and EAECV were prepared in the culture medium using two-fold dilution and added in 96-well plates in triplicate with 1% parasitemia and 5% HCT for B. divergens, B. caballi and T. equi and 2.5% HCT for B. bovis and B. bigemina. The positive control had DMSO at a final concentration of 0.3% and iRBCs, whereas uninfected RBCs and the culture medium served as the negative control. Subsequently, all parasites were incubated for 4 successive days without changing medium at 37 °C humidified multi-gas water-jacketed incubator in an atmosphere of 5% CO2, 5% O2, and 90% N2. On the fourth day of culture, an aliquot (100 µL) of lysis buffer containing 2 × SG1 was added to each well; thereafter, it was wrapped with aluminum foil to prevent direct exposure to light. After a 6-h incubation at room temperature, fluorescence readings were acquired on a spectrofluorimeter (Fluoroskan Ascent, Thermo Fisher Scientific, Oceanside, CA, USA) with excitation and emission wavelengths of 485 and 518 nm, respectively.
4.5. Viability Test and Morphological Changes
The viability studies were monitored via microscopy as described previously [6]. Briefly, an aliquot (20 µL) of iRBCs (1% parasitemia) was cultivated in 200 µL of media containing various concentrations of AECV and EAECV for 4 successive days, changing media daily. The concentrations used in this experiment were 0.25 ×, 0.5 ×, 1 ×, 2 ×, and 4 × the IC50. On the fifth day, a mixture of iRBCs (6 µL) from each well and fresh equine or bovine RBCs (14 µL) was transferred to a new 96-well plate, cultured in drug-free media and then left for an additional 8 days. The parasite prevalence was determined via light microscopy in order to evaluate parasite growth.
4.6. Cell Cultures
Cultures of Madin–Darby bovine kidney (MDBK) (ECACC), mouse embryonic fibroblast (NIH/3T3 ATCC® CRL-1658™) and human foreskin fibroblast (HFF HFF-1 ATCC® SCRC-1041™) cell lines were retrieved from −80 °C stock and cultured continuously in our laboratory under atmosphere 5% CO2 at 37 °C. The MDBK cell line was cultured in Minimum Essential Medium Eagle (MEM; Gibco, Grand Island, NY, USA), while NIH/3T3 and HFF cell lines were in Dulbecco Modified Eagle’s Medium (DMEM, Gibco). Each medium was treated with 1% glutamine, 10% fetal bovine serum, and 0.5% penicillin/streptomycin (Gibco). The medium was changed every 3 to 4 days, and once 80% confluence was reached, cells were harvested as per sub-culture protocol. To confirm the absence of mycoplasma contamination, 4,6-diamidino-2-phenylindole dihydrochloride (DAPI; Sigma-Aldrich, St. Louis, MO, USA) staining was used.
4.7. Cytotoxic Action of AECV and EAECV on Normal Cells
The cell viability assay was performed as described elsewhere [42,43]. Briefly, 100 µL of cells were seeded in a 96-well plate at a density of 5 × 104 cells/mL in DMEM or MEM with fetal bovine serum and incubated overnight under atmosphere 5% CO2 at 37 °C for attachment. Aliquots (10 µL) of two-fold AECV and EAECV dilutions were added to each well to attain final concentrations of 15.8 to 1000 µM in triplicate and incubated for an additional 24 h. The wells with only a culture medium were used as a negative control, while the wells containing cells and the medium with 0.4% DMSO were used as a positive control. After 24 h, 10 µL of Cell Counting Kits-8 (CCK-8) was added, and the plate was incubated for another 3 h. The absorbance was measured using a microplate reader at 450 nm.
4.8. In Vitro Drug Combination Test
The combination therapies of AECV and EAECV with DA were evaluated using the fluorescence assay in the in vitro culture of B. bovis, B. bigemina, B. divergens, B. caballi, and T. equi as reported previously elsewhere [30]. Briefly, two-drug combinations of AECV and EAECV with DA, MESA and MEOE at five selected concentrations 0.25 ×, 0.5 ×, 1 ×, 2 ×, and 4 × the IC50 were added in 96 well-plates in duplicate. The drug cultivation and the fluorescence values were calculated after adding a lysis buffer containing 2 × SGI to each well of the 96-well plate as described above. Combination index (CI) values were calculated using CompuSyn software and the degree of synergism was determined as the weighted average of CI values using the formulae, ((1 × IC50) + (2 × IC75) + (3 × IC90) + (4 × IC95))/10 and results were explained using the reference CI scale; lower than 0.90 was considered synergism, between 0.90–1.10 was considered additive, while higher than 1.10 was considered antagonism developed previously [44,45].
4.9. In Vivo Chemotherapeutic Effects of AECV and EAECV
AECV and EAECV were evaluated for in vivo growth-inhibition assay using B. microti–infected BALB/c mice according to a procedure described elsewhere [6,7]. Twenty-five 8-week-old female BALB/c mice were housed under a pathogen-free environment with controlled temperature (22 °C) and humidity and a 12 h light/dark cycle and randomly distributed into five groups. The mice in groups 2 through 5 received 0.5 mL of inoculum (1 × 107 B. microti iRBC) by intraperitoneal (i.p.) injection. Group 1 served as a negative control and was neither infected nor treated. At 1% parasitemia, drug treatment of the mice by i.p. started, continuing for five days. Group 2 served as a positive control and received 5% DMSO in DDW. Group 3 served as a reference drug control and received 25 mg/kg body weight (BW) of DA. Groups 4 and 5 received an oral administration of AECV and EAECV at 150 mg/kg, respectively. The levels of parasitemia were detected in all infected groups by microscopy using Giemsa-stained thin blood smears prepared every two days from venous tail blood until day 32 post-infection (p.i.).
The hematology profiles, including HCT percentage, HGB concentration, and number of RBCs were examined to detect the effect of C. verum extracts on the retrogression of anemia related to Babesia infection. The blood parameters were monitored by collecting 10 μL of mouse blood every 4 days using the Celltac α MEK-6450 automatic hematology analyzer (Celltac α MEK-6450, Nihon Kohden Corporation, Tokyo, Japan). After the in vivo inhibition assay, all mice were euthanized using an inhalation anesthesia system containing isoflurane by placing mice in the induction chamber, adjusting the oxygen flowmeter to 0.8 to 1.5 L/min and vaporizer to 3% to 5%. When mice were completely anesthetized, all of them were killed by cervical dislocation according to the ethical approval established by Fundamental Guidelines for Proper Conduct of Animal Experiment and Related Activities in Academic Research Institutions, the Ministry of Education, Culture, Sports and Technology (MEXT), Tokyo, Japan.
4.10. Ethical Statement
The in vivo studies were conducted based on the local guidelines for animal experimentation, as approved by the Obihiro University of Agriculture and Veterinary Medicine, Japan (accession numbers 28-111-2, 28-110, and 1417-2). This ethical approval was developed through the basic guidelines for the proper conduct of animal experimentation and related activities in Academic Research Institutions, Ministry of Education, Culture, Sports and Technology (MEXT), Japan.
4.11. Statistical Analysis
IC50 values of AECV, EAECV, DA, MESA, and MEOE was determined from the in vitro growth inhibition by nonlinear regression (curve fit) on a GraphPad Prism (GraphPad Software Inc., San Diego, CA, USA). The differences among group mean values on parasitemia and hematology profiles in the B. microti–infected mouse model were analyzed using a one-way ANOVA Tukey’s test in GraphPad Prism version 5.0. The difference was considered significant if p < 0.05 [46].
5. Conclusions
The current study showed the effectiveness of AECV and EAECV against the multiplication of several piroplasm parasites in vitro. C. verum extracts showed no apparent adverse effects in mice and showed efficacy in vitro, therefore, they could have potential value in treating clinical diseases caused by Babesia and Theileria in animals and humans. Taken together, these findings support that AECV and EAECV could be a potential source of alternate chemotherapy and discovering lead compounds that can be used for treatment of equine and bovine piroplasmosis as well as human babesiosis. However, further experiments are needed to evaluate the side effects of C. verum extracts on the histopathological and biochemical changes in different tissues and different times of treated mice.
Supplementary Materials
The following are available online. Table S1. IC50 and selectivity index of diminazene aceturate (DA), methanolic S. aromaticum (MESA) and methanolic O. europaea (MEOE). Figure S1. GC-MS report for compounds identified from AECV. Figure S2. GC-MS report for compounds identified from EAECV.
Author Contributions
Conceptualization, methodology, and writing subsequent drafts of the manuscript, G.E.-S.B. and A.M.B.; statistical analysis, the results analysis, and writing-original draft preparation A.G., A.N., T.M., and M.M.A.-D.; critical advice and supervised the study, I.I.; writing-review and editing G.E.-S.B., A.M.B., J.M. and I.I. All authors read and approved the final manuscript.
Funding
This study was supported by the Grant-in-Aid for Scientific Research (B) from MEXT KAKENHI (Grant Number 18H02337). In addition, this work was funded by the Researchers Supporting Project number (RSP 2019/ 121), King Saud University, Riyadh, Saudi Arabia.
Acknowledgments
This study was supported by the Grant-in-Aid for Scientific Research (B) from MEXT KAKENHI (Grant Number 18H02337). In addition, this work was funded by the Researchers Supporting Project number (RSP 2019/ 121), King Saud University, Riyadh, Saudi Arabia.
Conflicts of Interest
The authors declare that they have no competing interests.
Abbreviations
AECV: Acetonic extract of C. verum; EAECV: Ethyl acetate extract of C. verum; MDBK: Madin-Darby bovine kidney; NIH/3T3: Mouse embryonic fibroblast; HFF: Human foreskin fibroblast; IC50: Half maximal inhibitory concentration; EC50: Half maximum effective concentrations; DMSO: Dimethyl sulfoxide; DA: Diminazene aceturate; MESA: Methanolic extract of S. aromaticum; MEOE: Methanolic extract of O. europaea; EDTA: Ethylenediaminetetraacetic acid; RBCs: Red blood cells; M199: Medium 199; iRBCs: infected red blood cells; MEM: Minimum Essential Medium Eagle; DMEM: Dulbecco’s Modified Eagle’s Medium; CCK-8: Cell Counting Kit-8; CI: Combination index; DDW: Double distilled water; HGB: Hemoglobin; HCT: Hematocrit.
References
- Batiha, G.-S.; Beshbishy, A.M.; Adeyemi, O.S.; Nadwa, E.H.; Rashwan, E.M.; Alkazmi, L.M.; Elkelish, A.A.; Igarashi, I. Phytochemical screening and antiprotozoal effects of the methanolic Berberis vulgaris and acetonic Rhus coriaria extracts. Molecules 2020, 25, 550. [Google Scholar] [CrossRef]
- Beshbishy, A.M.; Batiha, G.E.S.; Alkazmi, L.; Nadwa, E.; Rashwan, E.; Abdeen, A.; Yokoyama, N.; Igarashi, I. Therapeutic Effects of Atranorin towards the Proliferation of Babesia and Theileria Parasites. Pathogens 2020, 9, 127. [Google Scholar] [CrossRef]
- Uilenberg, G. Babesia—A historical overview. Vet. Parasitol. 2006, 138, 3–10. [Google Scholar] [CrossRef]
- Batiha, G.E.; El-Far, A.H.; El-Mleeh, A.A.; Alsenosy, A.A.; Abdelsamei, E.K.; Abdel-Daim, M.M.; El-Sayed, Y.S.; Shaheen, H.M. In vitro study of ivermectin efficiency against the cattle tick, Rhipicephalus (Boophilus) annulatus, among cattle herds in El-Beheira, Egypt. Vet. World. 2019, 12, 1319–1326. [Google Scholar] [CrossRef]
- Vial, H.J.; Gorenflot, A. Chemotherapy against babesiosis. Vet. Parasitol. 2006, 138, 147–160. [Google Scholar] [CrossRef]
- Batiha, G.E.S.; Beshbishy, A.M.; Tayebwa, D.S.; Adeyemi, O.S.; Shaheen, H.; Yokoyama, N.; Igarashi, I. The effects of trans-chalcone and chalcone 4 hydrate on the growth of Babesia and Theileria. PLoS Negl. Trop. Dis. 2019, 13, e0007030. [Google Scholar] [CrossRef]
- Batiha, G.E.S.; Beshbishy, A.M.; Tayebwa, D.S.; Shaheen, M.H.; Yokoyama, N.; Igarashi, I. Inhibitory effects of Syzygium aromaticum and Camellia sinensis methanolic extracts on the growth of Babesia and Theileria parasites. Ticks Tick. Borne Dis. 2019, 10, 949–958. [Google Scholar] [CrossRef]
- Batiha, G.E.S.; Beshbishy, A.M.; Tayebwa, D.S.; Shaheen, M.H.; Yokoyama, N.; Igarashi, I. Inhibitory effects of Uncaria tomentosa bark, Myrtus communis roots, Origanum vulgare leaves and Cuminum cyminum seeds extracts against the growth of Babesia and Theileria in vitro. Jap. J. Vet. Parasitol. 2018, 17, 1–13. [Google Scholar]
- Beshbishy, A.M.; Batiha, G.E.S.; Adeyemi, O.S.; Yokoyama, N.; Igarashi, I. Inhibitory effects of methanolic Olea europaea and acetonic Acacia laeta on growth of Babesia and Theileria. Asia. Pac. J. Trop. Med. 2019, 12, 425–434. [Google Scholar]
- Batiha, G.-S.; Alkazmi, L.M.; Wasef, L.G.; Beshbishy, A.M.; Nadwa, E.H.; Rashwan, E.K. Syzygium aromaticum L. (Myrtaceae): Traditional uses, bioactive chemical constituents, pharmacological and toxicological activities. Biomolecules 2020, 10, 202. [Google Scholar] [CrossRef]
- Batiha, G.-S.; Alkazmi, L.M.; Nadwa, E.H.; Rashwan, E.K.; Beshbishy, A.M. Physostigmine: A plant alkaloid isolated from Physostigma venenosum: A review on pharmacokinetics, pharmacological and toxicological activities. J. Drug Deliv. Therap. 2020, 10. [Google Scholar] [CrossRef]
- Batiha, G.S.; Beshbishy, A.M.; El-Mleeh, A.; Abdel-Daim, M.M.; Devkota, H.P. Traditional uses, bioactive chemical constituents, and pharmacological and toxicological activities of Glycyrrhiza glabra L. (Fabaceae). Biomolecules 2020. accepted. [Google Scholar]
- Muthuswamy, S.; Rupasinghe, H.P.V.; Stratton, G.W. Antimicrobial effect of cinnamon bark on Escherichia coli O157:H7, Listeria innocua and fresh-cut apple slices. J. Food Saf. 2008, 28, 534–549. [Google Scholar] [CrossRef]
- Gunawardena, D.; Karunaweera, N.; Lee, S.; van Der Kooy, F.; Harman, D.G.; Raju, R.; Bennett, L.; Gyengesi, E.; Sucher, N.J.; Münch, G. Anti-inflammatory activity of cinnamon (C. zeylanicum and C. cassia) extracts—Identification of E-cinnamaldehyde and o-methoxy cinnamaldehyde as the most potent bioactive compounds. Food Funct. 2015, 6, 910–919. [Google Scholar] [CrossRef]
- Zhang, C.; Fan, L.; Fan, S.; Wang, J.; Luo, T.; Tang, Y.; Chen, Z.; Yu, L. Cinnamomum cassia Presl: A Review of Its Traditional Uses, Phytochemistry, Pharmacology and Toxicology. Molecules 2019, 24, 3473. [Google Scholar] [CrossRef]
- Barros, F.J.; Costa, R.J.O.; Cesário, F.R.A.S.; Rodrigues, L.B.; da Costa, J.G.M.; Coutinho, H.D.M.; Galvao, H.B.F.; de Menezes, I.R.A. Activity of essential oils of Piper aduncum anf and Cinnamomum zeylanicum by evaluating osmotic and morphologic fragility of erythrocytes. Europ. J. Integr. Med. 2016, 8, 505–512. [Google Scholar] [CrossRef]
- Kumar, S.; Kumari, R.; Mishra, S. Pharmacological properties and their medicinal uses of Cinnamomum: A review. J. Pharm. Pharmacol. 2019, 71, 1735–1761. [Google Scholar] [CrossRef]
- Sharma, U.K.; Sharma, A.K.; Pandey, A.K. Medicinal attributes of major phenylpropanoids present in cinnamon. BMC Complement. Altern. Med. 2016, 16, 156. [Google Scholar] [CrossRef]
- Ho, S.C.; Chang, K.S.; Chang, P.W. Inhibition of neuroinflammation by cinnamon and its main components. Food Chem. 2013, 138, 2275–2282. [Google Scholar] [CrossRef]
- Ling, F.; Jiang, C.; Liu, G.; Li, M.; Wang, G. Anthelmintic efficacy of cinnamaldehyde and cinnamic acid from cortex cinnamon essential oil against Dactylogyrus intermedius. Parasitology 2015, 142, 1744–1750. [Google Scholar] [CrossRef]
- Nkanwen, E.R.S.; Awouafack, M.D.; Bankeu, J.J.K.; Wabo, H.K.; Awad, S.; Mustafa, S.A.A.; Ali, M.S.; Lamshöft, M.; Choudhary, M.I.; Spiteller, M.; et al. Constituents from the stem bark of Cinnamomum zeylanicum Welw. (Lauraceae) and their inhibitory activity toward Plasmodium falciparum enoyl-ACP reductase enzyme. J. Rec. Nat. Prod. 2013, 7, 296–301. [Google Scholar]
- Parvazi, S.; Sadeghi, S.; Azadi, M.; Mohammadi, M.; Arjmand, M.; Vahabi, F.; Sadeghzadeh, S.; Zamani, Z. The effect of aqueous extract of cinnamon on the metabolome of Plasmodium falciparum using 1HNMR spectroscopy. J. Trop. Med. 2016, 2016, 1–5. [Google Scholar] [CrossRef][Green Version]
- Satya, N.; Prakash, S.; Meena, V. Purification of cinnamaldehyde from cinnamon species by column chromatography. Int. Res. J. Biol. Sci. 2012, 1, 49–51. [Google Scholar]
- Kwan, H.Y.; Wu, J.; Su, T.; Chao, X.J.; Liu, B.; Fu, X.; Chan, C.L.; Lau, R.H.Y.; Tse, A.K.W.; Han, Q.B.; et al. Cinnamon induces browning in subcutaneous adipocytes. Sci. Rep. 2017, 7, 2447. [Google Scholar] [CrossRef]
- Dvorackova, E.; Snoblova, M.; Chromcova, L.; Hrdlicka, P. Effects of extraction methods on the phenolic compounds contents and antioxidant capacities of cinnamon extracts. Food Sci. Biotechnol. 2015, 24, 1201–1207. [Google Scholar] [CrossRef]
- Wink, M. Medicinal plants: A source of anti-parasitic secondary metabolites. Molecules 2012, 17, 12771–12791. [Google Scholar] [CrossRef]
- Von Son-de Fernex, E.; Alonso-Díaz, M.Á.; Valles-de la Mora, B.; Mendoza-de Gives, P.; González-Cortazar, M.; Zamilpa, A. Anthelmintic effect of 2H-chromen-2-one isolated from Gliricidia sepium against Cooperia punctata. Exp. Parasitol. 2017, 178, 1–6. [Google Scholar] [CrossRef]
- Williams, A.R.; Ramsay, A.; Hansen, T.V.; Ropiak, H.M.; Mejer, H.; Nejsum, P.; Mueller-Harvey, I.; Thamsborg, S.M. Anthelmintic activity of trans-cinnamaldehyde and A-and B-type proanthocyanidins derived from cinnamon (Cinnamomum verum). Sci. Rep. 2015, 5, 14791. [Google Scholar] [CrossRef]
- Kpadonou, D.; Kpoviessi, S.; Bero, J.; Agbani, P.; Gbaguidi, F.; Kpadonou-Kpoviessi, B.; Sinsin, B.; Frédérich, M.; Quetin-Leclercq, J. Chemical composition, in vitro antioxidant and antiparasitic properties of the essential oils of three plants used in traditional medicine in Benin. J. Med. Plant. Res. 2019, 13, 384. [Google Scholar]
- Bosquiroli, L.S.; Demarque, D.P.; Rizk, Y.S.; Cunhac, M.C.; Marquesd, M.C.S.; Matos, M.F.C.; Kadrie, M.C.T.; Carollob, C.A.; Arruda, C.C.P. In vitro anti-Leishmania infantum activity of essential oil from Piper angustifolium. Rev. Bras. Farmacogn. 2015, 25, 124–128. [Google Scholar] [CrossRef]
- Le, T.B.; Beaufay, C.; Bonneau, N.; Mingeot-Leclercq, M.P.; Quetin-Leclercq, J. Anti-protozoal activity of essential oils and their constituents against Leishmania, Plasmodium and Trypanosoma. Phytochimie 2018, 1, 1–33. [Google Scholar]
- Hamidpour, R.; Hamidpour, M.; Hamidpour, S.; Shahlari, M. Cinnamon from the selection of traditional applications to its novel effects on the inhibition of angiogenesis in cancer cells and prevention of Alzheimer’s disease, and a series of functions such as antioxidant, anticholesterol, antidiabetes, antibacterial, antifungal, nematicidal, acaracidal, and repellent activities. J. Tradit. Complement. Med. 2015, 5, 66–70. [Google Scholar] [PubMed]
- Plata-Rueda, A.; Campos, J.M.; da Silva Rolim, G.; Martínez, L.C.; Dos Santos, M.H.; Fernandes, F.L.; Serrão, J.E.; Zanuncio, J.C. Terpenoid constituents of cinnamon and clove essential oils cause toxic effects and behavior repellency response on granary weevil, Sitophilus granarius. Ecotoxicol. Environ. Saf. 2018, 156, 263–270. [Google Scholar] [CrossRef] [PubMed]
- Batiha, G.E.S.; Beshbishy, A.M.; Tayebwa, D.S.; Adeyemi, O.S.; Shaheen, H.; Yokoyama, N.; Igarashi, I. Anti-piroplasmic potential of the methanolic Peganum harmala seeds and ethanolic Artemisia absinthium leaf extracts. J. Protozool. Res. 2019, 29, 8–27. [Google Scholar]
- Mazimba, O.; Wale, K.; Kwape, T.E.; Mihigo, S.O.; Kokengo, B.M. Cinnamomum verum: Ethyl acetate and methanol extracts antioxidant and antimicrobial activity. J. Med. Plants Stud. JMPS 2015, 28, 28–32. [Google Scholar]
- Mathew, S.; Abraham, T.E. Studies on the antioxidant activities of cinnamon (Cinnamomum verum) bark extracts, through various in vitro models. Food Chem. 2006, 94, 520–528. [Google Scholar] [CrossRef]
- Kucukkurt, I.; Cigerci, I.H.; Ince, S.; Kozan, E.; Aytekin, I.; Eryavuz, A.; Fidan, A.F. The effects of babesiosis on oxidative stress and DNA damage in Anatolian Black goats naturally infected with Babesia ovis. Iran. J. Parasitol. 2014, 9, 90–98. [Google Scholar]
- Islam, M.R.; Naima, J.; Proma, N.M.; Hussain, M.S.; Naim Uddin, S.M.; Hossain, M.K. In-vivo and in-vitro evaluation of pharmacological activities of Ardisia solanacea leaf extract. Clin. Phytosci. 2019, 5, 32. [Google Scholar] [CrossRef]
- Bolanle, A.O.; Funmilola, A.S.; Adedayo, A. Proximate analysis, mineral contents, amino acid composition, anti-nutrients and phytochemical screening of Brachystegia eurycoma harms and Pipper Guineense Schum and Thonn. Am. J. Food Nutr. 2014, 2, 11–17. [Google Scholar]
- Hassan, L.E.; Ahamed, M.B.; Majid, A.S.; Baharetha, H.M.; Muslim, N.S.; Nassar, Z.D.; Majid, A.M. Correlation of antiangiogenic, antioxidant and cytotoxic activities of some Sudanese medicinal plants with phenolic and flavonoid contents. BMC Complement. Altern. Med. 2014, 14, 406. [Google Scholar] [CrossRef]
- Batiha, G.-S.; Beshbishy, A.M.; Alkazmi, L.M.; Adeyemi, O.S.; Nadwa, E.H.; Rashwan, E.K.; El-Mleeh, A.; Igarashi, I. Gas chromatography-mass spectrometry analysis, phytochemical screening and antiprotozoal effects of the methanolic Viola tricolor and acetonic Laurus nobilis extracts. BMC Complement. Altern. Med. 2020, in press. [Google Scholar]
- Lu, Y.; Cai, Y.C.; Chen, S.H.; Chen, J.X.; Guo, J.; Chen, M.X.; Ai, L.; Chu, Y.H.; Chen, Z.; Zhou, X.N. Establishment of the experimental animal model of Babesia microti. Chin. J. Parasitol. Parasit. Dis. 2012, 30, 423–427. [Google Scholar]
- Beshbishy, A.M.; Batiha, G.E.S.; Yokoyama, N.; Igarashi, I. Ellagic acid microspheres restrict the growth of Babesia and Theileria in vitro and Babesia microti in vivo. Parasites Vectors 2019, 12, 269. [Google Scholar] [CrossRef]
- Batiha, G.E.S.; Beshbishy, A.M.; Tayebwa, D.S.; Adeyemi, O.S.; Yokoyama, N.; Igarashi, I. Evaluation of the inhibitory effect of ivermectin on the growth of Babesia and Theileria parasites in vitro and in vivo. Trop. Med. Health 2019, 47, 42. [Google Scholar] [CrossRef] [PubMed]
- Chou, T.C. Theoretical basis, experimental design, and computerized simulation of synergism and antagonism in drug combination studies. Pharmacol. Rev. 2006, 58, 621–681. [Google Scholar] [CrossRef] [PubMed]
- Batiha, G.E.S.; Beshbishy, A.M.; Adeyemi, O.S.; Nadwa, E.H.; Rashwan, E.k.M.; Yokoyama, N.; Igarashi, I. Safety and efficacy of hydroxyurea and eflornithine against most blood parasites Babesia and Theileria. PLoS ONE 2020, 15, e0228996. [Google Scholar]
Sample Availability: Samples of the extracts and all data generated and/or analyzed during the present study are available from the corresponding author upon reasonable request. |
© 2020 by the authors. Licensee MDPI, Basel, Switzerland. This article is an open access article distributed under the terms and conditions of the Creative Commons Attribution (CC BY) license (http://creativecommons.org/licenses/by/4.0/).